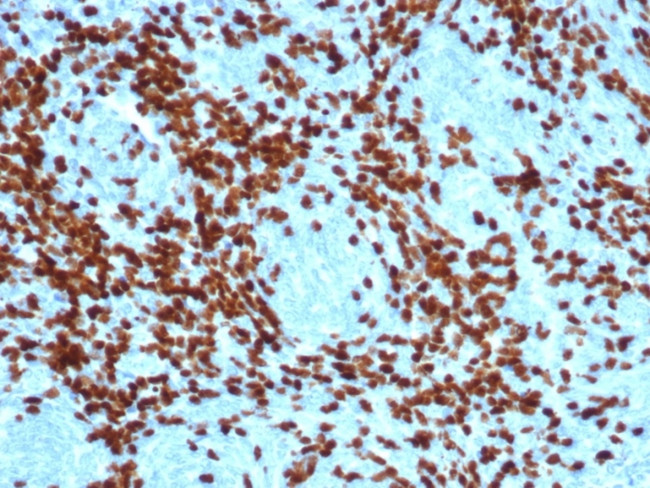
TdT/DNA Nucleotidylexotransferase (Acute Lymphoblastic Leukemia Marker) Antibody in Immunohistochemistry (Paraffin) (IHC (P))

Search
NeoBiotechnologies
TdT/DNA Nucleotidylexotransferase (Acute Lymphoblastic Leukemia Marker) Recombinant Rabbit Monoclonal Antibody (DNTT/4617R)
{{$productOrderCtrl.translations['antibody.pdp.commerceCard.promotion.promotions']}}
{{$productOrderCtrl.translations['antibody.pdp.commerceCard.promotion.viewpromo']}}
{{$productOrderCtrl.translations['antibody.pdp.commerceCard.promotion.promocode']}}: {{promo.promoCode}} {{promo.promoTitle}} {{promo.promoDescription}}. {{$productOrderCtrl.translations['antibody.pdp.commerceCard.promotion.learnmore']}}
产品信息
1791-RBM7-P0
种属反应
宿主/亚型
Expression System
分类
类型
克隆号
抗原
偶联物
形式
浓度
规格
纯化类型
保存液
内含物
保存条件
运输条件
靶标信息
Terminal Deoxynucleotidyl Transferase (TdT) is a DNA polymerase located in the cell nucleus which catalyses the polymerization of deoxynucleotides at the 3' hydroxyl ends of oligo or polydeoxynucleotide initiators and functions without a template. TdT is considered to be a highly specific marker for the diagnosis and classification of acute lymphoblastic lymphoma/leuksemias. The determination of TdT expression is most valuable when it is different to differentiate histologically between lymphoblastic lymphoma and Burkitt's lymphoma.
仅用于科研。不用于诊断过程。未经明确授权不得转售。
篇参考文献 (0)
生物信息学
蛋白别名: Deoxynucleotidyltransferase terminal; DNA nucleotidylexotransferase; Nucleosidetriphosphate DNA Deoxynucleotidylexotransferase; nucleosidetriphosphate:DNA deoxynucleotidylexotransferase; Terminal addition enzyme; Terminal deoxynucleotidyltransferase; terminal deoxyribonucleotidyltransferase; Terminal transferase
基因别名: DNTT; TDT
UniProt ID: (Human) P04053
Entrez Gene ID: (Human) 1791